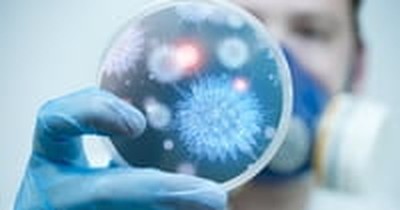

Are You Being Infected by the World?
Spiritual Life

Audio By Carbonatix
By Shane Idleman, Crosswalk.com
"Now he who received seed among the thorns is he who hears the word, and the cares of this world and the deceitfulness of riches choke the word, and he becomes unfruitful."
Matthew 13:22
Throughout history, Christians have vacillated between two extremes: compromising with the culture or removing themselves from it (isolation). Neither extreme is healthy. But the focus of this article is on “the cares of this world”—being so ingrained in the culture that we are unproductive for Christ.
Scripture is clear, our lifestyle should reflect God’s heart rather than the world’s influence. The world will know that we are Christians by our love for one another and by our obedience, not by how well we imitate the world around us. Oswald Chambers once noted that a sinner, who is now saved by grace, “proves he is forgiven by being the opposite of who he was.” He no longer resembles the sinful world that use to sway his heart.
Carnal Christians give God “His due” (a few hours on Sunday), but they forget His call to “come out from among them (the world) and be separate.” Is the world influencing you? What does your mental media diet consist of? Who do you hang out with? What, and who, do you listen to? Is your heart set toward the things of God or the world’s influence? A quick peruse of your LIKEs and posts on Facebook will reveal a great deal.
Many go to church sporadically, but would rather sit at home. They are disengaged and bored during worship when they do attend. Their social media posts resemble Hollywood not the work of the Spirit. They choose friends who complement their worldly lifestyle, rather than friends who challenge them to live for God. They prefer wine tasting at Bible studies versus an in depth study. The things of the world are exciting and the things of God are dull. Be clear here: the cares of this world will draw you (and me) away from our relationship with God if we allow them to.
James 1:22 reminds us that if we listen to God’s word without applying it, that we are fooling ourselves... we are deceived. The power of God’s word lies in the application. In addition to non-Christians, it is Christians who are moving sexually explicit and violent movies to the Top 10 by not applying purity to their lives. It is Christians who are addicted to porn and supplying the revenue to fuel the industry.
I often remind our congregation that we can either make our homes a holy sanctuary that honors Christ, or a breeding ground for Satan. That’s a hard statement but it’s true: we cannot love both Christ and this world. Carnality has a cost. In times past, the hero was the father, not Edward (from Twilight). The greatest influence was the mother, not Bella. Kids once quoted Scriptures; now they are casting spells.
Don’t get me wrong: We are to examine our own lives and motives first, and then we are to be moved primarily by love for God and others before critiquing. Jesus said in Matthew 7:5 that we must first remove theplank from our own eye, and then we will see clearly to removethe speck from our brother’s eye.Avoiding the cares of this world is a struggle for all of us. We are constantly swimming upstream against the cultural tide. The fact that there is a struggle demonstrates the importance of victory.
Are you being infected by the world? Being infected is the ultimate cost of carnality! Like any infection, it can destroy the body, and, in this case, the soul. When we are infected, we infect others. Parents, what influences are you allowing in to your home... into the minds of your children? Things that are pure, noble, and true, or dark, demonic, and false?
Carnality destroys our relationship with Christ and genuine fellowship with other believers. It destroys our prayer life as well. A carnal Christian does not pray, really pray and seek the heart of God. A deep prayer life exposes facades and crushes hypocrisy. Carnality also destroys spiritual power and hinders the infilling of the Spirit. In short, everything that God calls us to be is compromised.
When Jesus said that we are “the salt and light of the earth,” He was saying that we should have a preserving and cleansing effect on the culture... we should bring a purifying aspect to all areas of life. Light dispels darkness; it does not cater to it. The purpose of this article isn’t to upset; ultimately, it’s to foster repentance and a deeper walk with God.
On a closing note, carnality not only affects the pew, but the pulpit as well. A carnal pastor still offers motivating sermons, but he will lose unction, boldness, and spiritual insight. The world, and carnal Christians, will love him, but Spirit-filled believers will leave the service starving for more of God. Pastors, if we would make it our goal to know Christ more personally we would preach Christ more powerfully. Are we calling people out of the cultural mindset or are we encouraging it by our silence?
At this point you may think, “Why try? This is hopeless! I’ve drifted too far.” Let me reassure you: God doesn’t let our relationship with Him hinge on “measuring up,” or on “following rules.” He wants us to come as we are, recognize our need for a Savior, and commit our life completely to Him. Simply repent of this destructive lifestyle, and begin making choices that promote holiness and purity. Change is God’s job, but obedience is ours.
Shane Idleman is the founder and lead pastor of Westside Christian Fellowship, in Lancaster, Ca. His sermons, books, articles, and radio program have sparked change in the lives of many. For more, visit WCFAV.org, or ShaneIdleman.com Follow us on Facebook at https://www.facebook.com/WCFAV
Publication date: June 26, 2017
Photo credit: ©Thinkstock/solarseven
This content first appeared on Crosswalk.com and is used here with permission. To view the original visit: https://www.crosswalk.com/faith/spiritual-life/are-you-being-infected-by-the-world.html


